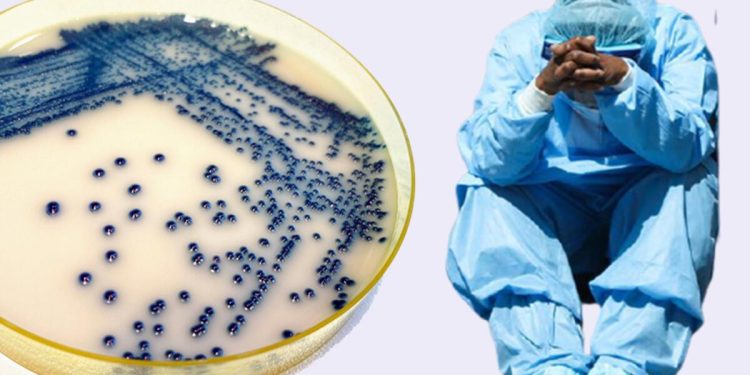
ABD uyarı yayınladı: Hızla yayılıyor! Ünlü dizi ile korkutan benzerlik…

CDC datalarına nazaran ‘Candida auris’ olarak bilinen mantar enfeksiyonları 2019 yılında 476 olaydan 2021 yılında Escort Sancaktepe 1 471’e çıktı
Mantarı taşıyan fakat enfekte olmayan insanların sayısı birebir vakit diliminde neredeyse dört katına çıkarak 1 077’den 4 040’a çıktı Ön datalar olay sayısının artmaya devam ettiğini ve Sancaktepe Escort antibiyotiğe dirençli suşların ortaya çıktığını gösteriyor
ÖLÜM ORANI YÜZDE 30 İLE 70 ORTASINDA DEĞİŞİYOR
Bilim insanları mantarın bağışıklık sistemleri güçlü sağlıklı beşerler için bir tehdit olmadığına inanıyor
Ancak teneffüs aygıtına Sancaktepe Escort Bayan bağlı hastalar ve kemoterapi gören kanser hastaları üzere tıbbi olarak daha hassas bireyler önemli risk altında
Mantar nedeni ile septisemi kan sirkülasyonu enfeksiyonu geliştiren hastaların yüzde 30 ila 70’inin hayatını kaybettiği öldüğü varsayım ediliyor
TEMİZLENMESİ ÇOK ZOR SAĞLAM BİR PLANA MUHTAÇLIĞIMIZ VAR
CDC uzmanları hastalık objelerle temas yoluyla yayıldığı için muhtemel bir salgına karşı sağlam bir enfeksiyon denetim planına muhtaçlık duyulduğunun altını çiziyor
Vanderbilt Üniversitesi’nden bulaşıcı hastalıklar profesörü William Schaffner Mantarlar bir hastaneye girdiklerinde denetim edilmeleri ve temizlenmeleri hayli zordur derken CDC’den Meghan Lyman mantarın yüzeylerde uzun müddet kalmasından ötürü temizlenmesinin güç olduğunu ve hastanelerdeki kimi dezenfektanların bu mantara karşı etkisiz olduğunu vurguladı
HALK SIHHATİ İÇİN ÖNEMLİ BİR GLOBAL TEHDİT
Candida mantarı ABD’de birinci defa 2016 yılında tespit edildi 2019 yılında farklı sınıflardaki mantar önleyici ilaçlara dirençli olduğu için önemli bir ‘küresel halk sıhhati tehdidi’ olarak kabul edildi
Mantarlar çoklukla insan bedeninin sıcaklığına dayanamaz On yılı aşkın bir müddet evvel Hindistan Güney Afrika ve Güney Amerika’da tespit edilen mantarın ortaya çıkışı sonrası yapılan araştırmalar Candida’nın ısınan bir dünyada hayatta kalmak için evrimleştiğini öne sürüyor
ÜNLÜ DİZİ İLE KORKUTAN BENZERLİK
Mikrobiyolog Arturo Casadevall iklim değişikliği yahut global ısınmanın hastalıkları da beraberinde getirdiğine dikkat çekerek Çevre kaideleri değiştikçe virüs ve mantar üzere canlılar insan bedeninde hayatta kalabilmek için yeni kurallara ahenk sağlıyor dedi
ABD’den mantar hastalığı ile ilgili yapılan ikazın son devirlerin tanınan dizisi ‘The Last Of Us’ ile ürkütücü paralellikler içermesi Casadevall’ın dikkatinden kaçmıyor ve latife ile karışık bir biçimde insanların telaşlarını gideriyor
Söz konusu mantarın insanların zombiye dönüşmesine neden olmadığını bildirmekten memnuniyet duyuyoruz
ABD Hastalık Denetim ve Tedbire Merkezleri (CDC) dün yaptığı açıklama ile ölümcül ve ilaca karşı epey dirençli bir mantarın uzun vadeli bakım hastanelerinde ve öteki sıhhat tesislerinde “endişe verici bir hızla” yayıldığını duyurdu.
ÖLÜMCÜL ENFEKSİYONLARA NEDEN OLABİLİR
‘C auris’ olarak da bilinen ‘Candida auris’ kan sirkülasyonunda kalpte ve beyinde ölümcül enfeksiyonlara neden olabilir
Uzmanlar ölümcül potansiyeline karşın hastanelerin uygun dezenfektanlarla derinlemesine temizlenmesi durumunda Candida’nın yayılmasının durdurulabileceğine inanıyor